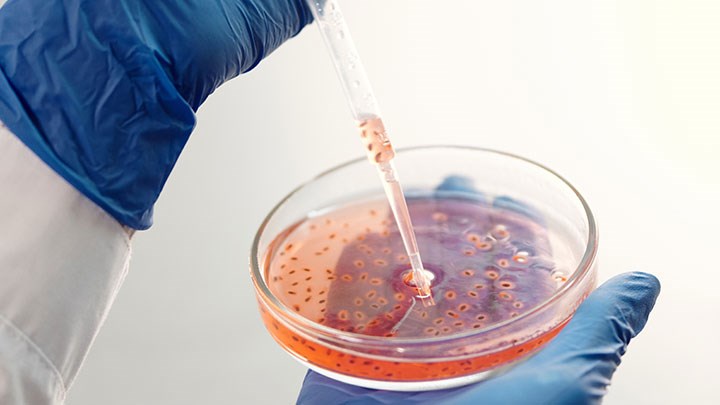
BioImpakt.

Örebro University Holding – investing in innovation

At a creative environment like Örebro University, ideas of all sizes emerge about how to make the world better. Some of these ideas eventually develop into companies. To give these companies the best conditions to grow and create impact, Örebro University Holding invests in companies founded by researchers and students. Through expertise and financial support, Holding increases the chances for innovators to build successful businesses.
Since 2015, Örebro University Holding has invested in research-based companies with the potential to create societal impact, across several academic disciplines. Thanks to the university’s strong research in AI and robotics, many of these companies originate from computer science, but the portfolio also includes companies in medicine, criminology, chemistry, biology, biomedicine, culinary arts, mechanical engineering and education.
Following two exits, Örebro University Holding’s portfolio currently consists of 15 companies.